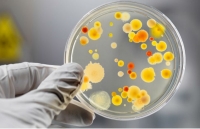

В детском саду Сосновки вспышка сальмонеллеза
ЧП в детском саду случилось еще в феврале, известно о нем стало только в марте.
На сегодня выявлено 11 заболевших, 9 детей находятся на лечении в больнице.
"По всей видимости, кто-то из детей и стал распространителем заболевания, потому что на кухне проверили всех сотрудников, возбудителя не нашли. Остается только сторож, которого мы пока не обследовали, потому что не знаем, где он", - приводит слова главы Вологодского района Сергей Жестянников ИА "Ранпресс".
Было обследовано 190 человек. Детский сад после обработки открыт и работает в штатном режиме.
Сальмонеллез – это разновидность пищевого отравления, инфекционное заболевание. Заражение чаще всего происходит при употреблении в пищу некачественных или несвежих продуктов. Взрослый человек может получить заболевание, употребляя в пищу куриные яйца, молоко, мясо, сливочное масло, сообщает ИА "СеверИнформ".